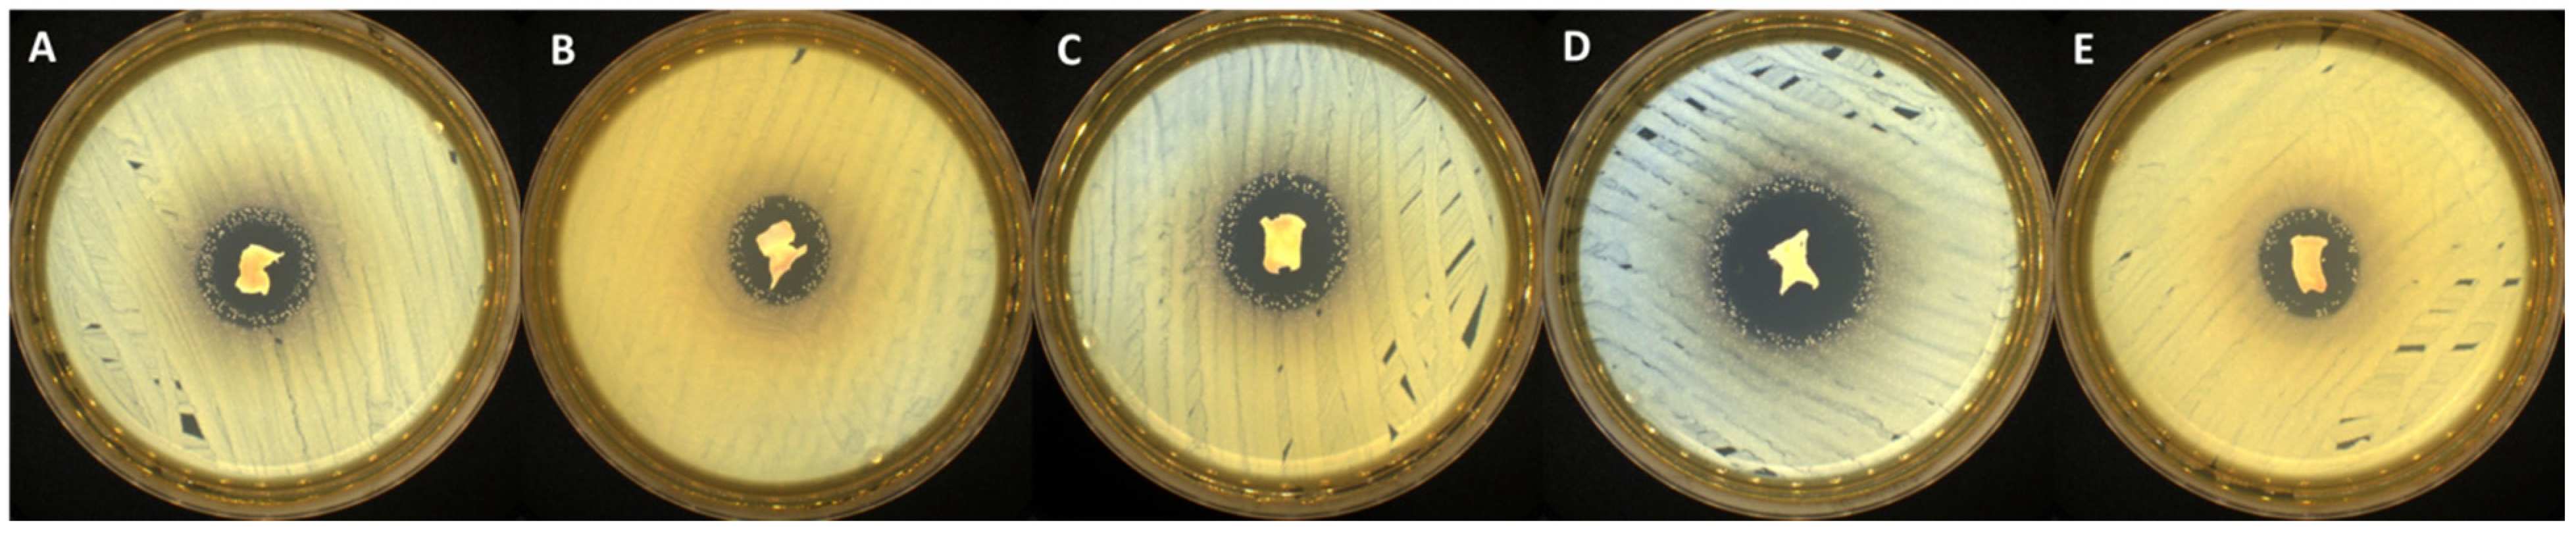
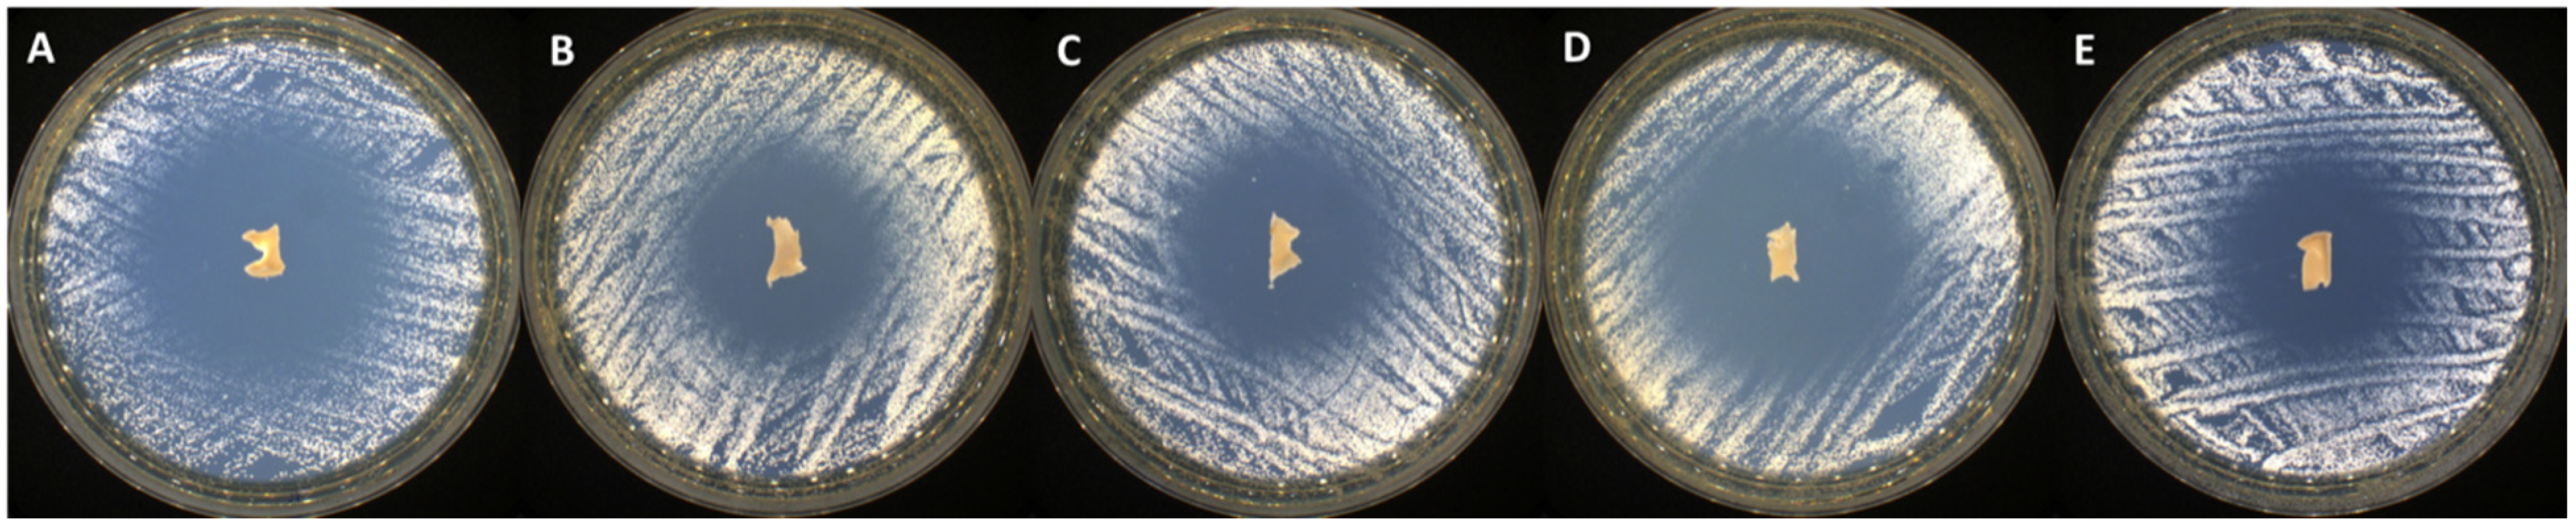

Cryogel System Based on Poly(vinyl alcohol)/Poly(ethylene brassylate-co-squaric acid) Platform with Dual Bioactive Activity
Abstract
1. Introduction
2. Results and Discussion
2.1. Morphological Analysis
2.2. Release Studies
2.3. Antimicrobial Activity
2.4. Antioxidant Efficiency
3. Conclusions
4. Materials and Methods
4.1. Materials
4.2. Preparation of Cryogels by In Situ Entrapment of Thymol and α-Tocopherol
4.3. Characterization
4.3.1. Morphological Analysis
4.3.2. Release Studies
4.3.3. Antimicrobial Activity
4.3.4. Antioxidant Efficiency
4.3.5. Statistical Analysis
Author Contributions
Funding
Conflicts of Interest
References
- Enoch, S.; Leaper, D.J. Basic Science of Wound Healing. Surgery 2008, 26, 31–37. [Google Scholar] [CrossRef]
- Velnar, T.; Bailey, T.; Smrkolj, V. The Wound Healing Process: An Overview of the Cellular and Molecular Mechanisms. J. Int. Med. Res. 2009, 37, 1528–1542. [Google Scholar] [CrossRef] [PubMed]
- Aguilar, T.A.F.; HernándezNavarro, B.C.; Pérez, J.A.M.; Aguilar, T.A.F.; HernándezNavarro, B.C.; Pérez, J.A.M. Endogenous Antioxidants: A Review of Their Role in Oxidative Stress; IntechOpen: London, UK, 2016; ISBN 978-953-51-2838-0. [Google Scholar]
- Na, Y.; Woo, J.; Choi, W.I.; Lee, J.H.; Hong, J.; Sung, D. α-Tocopherol-Loaded Reactive Oxygen Species-Scavenging Ferrocene Nanocapsules with High Antioxidant Efficacy for Wound Healing. Int. J. Pharm. 2021, 596, 120205. [Google Scholar] [CrossRef]
- Comino-Sanz, I.M.; López-Franco, M.D.; Castro, B.; Pancorbo-Hidalgo, P.L. The Role of Antioxidants on Wound Healing: A Review of the Current Evidence. JCM 2021, 10, 3558. [Google Scholar] [CrossRef] [PubMed]
- Roehrs, M.; Valentini, J.; Paniz, C.; Moro, A.; Charão, M.; Bulcão, R.; Freitas, F.; Brucker, N.; Duarte, M.; Leal, M.; et al. The Relationships between Exogenous and Endogenous Antioxidants with the Lipid Profile and Oxidative Damage in Hemodialysis Patients. BMC Nephrol. 2011, 12, 59. [Google Scholar] [CrossRef] [PubMed]
- Srivastava, S.; Phadke, R.S.; Govil, G.; Rao, C.N.R. Fluidity, Permeability and Antioxidant Behaviour of Model Membranes Incorporated with α-Tocopherol and Vitamin E Acetate. Biochim. Et Biophys. Acta (BBA)-Biomembr. 1983, 734, 353–362. [Google Scholar] [CrossRef]
- Bonferoni, M.C.; Riva, F.; Invernizzi, A.; Dellera, E.; Sandri, G.; Rossi, S.; Marrubini, G.; Bruni, G.; Vigani, B.; Caramella, C.; et al. Alpha Tocopherol Loaded Chitosan Oleate Nanoemulsions for Wound Healing. Evaluation on Cell Lines and Ex Vivo Human Biopsies, and Stabilization in Spray Dried Trojan Microparticles. Eur. J. Pharm. Biopharm. 2018, 123, 31–41. [Google Scholar] [CrossRef]
- Gonnet, M.; Lethuaut, L.; Boury, F. New Trends in Encapsulation of Liposoluble Vitamins. J. Control. Release 2010, 146, 276–290. [Google Scholar] [CrossRef]
- Haleem, A.; Chen, S.-Q.; Ullah, M.; Siddiq, M.; He, W.-D. Highly Porous Cryogels Loaded with Bimetallic Nanoparticles as an Efficient Antimicrobial Agent and Catalyst for Rapid Reduction of Water-Soluble Organic Contaminants. J. Environ. Chem. Eng. 2021, 9, 106510. [Google Scholar] [CrossRef]
- Ambreen, J.; Haleem, A.; Shah, A.A.; Mushtaq, F.; Siddiq, M.; Bhatti, M.A.; Shah Bukhari, S.N.U.; Chandio, A.D.; Mahdi, W.A.; Alshehri, S. Facile Synthesis and Fabrication of NIPAM-Based Cryogels for Environmental Remediation. Gels 2023, 9, 64. [Google Scholar] [CrossRef]
- Wang, M.; Bai, J.; Shao, K.; Tang, W.; Zhao, X.; Lin, D.; Huang, S.; Chen, C.; Ding, Z.; Ye, J. Poly(Vinyl Alcohol) Hydrogels: The Old and New Functional Materials. Int. J. Polym. Sci. 2021, 2021, 2225426. [Google Scholar] [CrossRef]
- Nita, L.E.; Crețu, B.-E.-B.; Șerban, A.-M.; Rusu, A.G.; Rosca, I.; Pamfil, D.; Chiriac, A.P. New Cryogels Based on Poly (Vinyl Alcohol) and a Copolymacrolactone System. II. Antibacterial Properties of the Network Embedded with Thymol Bioactive Agent. React. Funct. Polym. 2023, 182, 105461. [Google Scholar] [CrossRef]
- Nagoor Meeran, M.F.; Javed, H.; Al Taee, H.; Azimullah, S.; Ojha, S.K. Pharmacological Properties and Molecular Mechanisms of Thymol: Prospects for Its Therapeutic Potential and Pharmaceutical Development. Front. Pharmacol. 2017, 8, 380. [Google Scholar] [CrossRef] [PubMed]
- Braga, P.C.; Dal Sasso, M.; Culici, M.; Bianchi, T.; Bordoni, L.; Marabini, L. Anti-Inflammatory Activity of Thymol: Inhibitory Effect on the Release of Human Neutrophil Elastase. Pharmacology 2006, 77, 130–136. [Google Scholar] [CrossRef]
- Marchese, A.; Orhan, I.E.; Daglia, M.; Barbieri, R.; Di Lorenzo, A.; Nabavi, S.F.; Gortzi, O.; Izadi, M.; Nabavi, S.M. Antibacterial and Antifungal Activities of Thymol: A Brief Review of the Literature. Food Chem. 2016, 210, 402–414. [Google Scholar] [CrossRef]
- Escobar, A.; Pérez, M.; Romanelli, G.; Blustein, G. Thymol Bioactivity: A Review Focusing on Practical Applications. Arab. J. Chem. 2020, 13, 9243–9269. [Google Scholar] [CrossRef]
- Najafloo, R.; Behyari, M.; Imani, R.; Nour, S. A Mini-Review of Thymol Incorporated Materials: Applications in Antibacterial Wound Dressing. J. Drug Deliv. Sci. Technol. 2020, 60, 101904. [Google Scholar] [CrossRef]
- Chiriac, A.P.; Rusu, A.G.; Nita, L.E.; Macsim, A.-M.; Tudorachi, N.; Rosca, I.; Stoica, I.; Tampu, D.; Aflori, M.; Doroftei, F. Synthesis of Poly(Ethylene Brassylate-Co-Squaric Acid) as Potential Essential Oil Carrier. Pharmaceutics 2021, 13, 477. [Google Scholar] [CrossRef]
- Crețu, B.-E.-B.; Nita, L.E.; Șerban, A.-M.; Rusu, A.G.; Doroftei, F.; Chiriac, A.P. New Cryogels Based on Poly(Vinyl Alcohol) and a Copolymacrolactone System: I-Synthesis and Characterization. Nanomaterials 2022, 12, 2420. [Google Scholar] [CrossRef] [PubMed]
- Chiriac, A.P.; Asandulesa, M.; Stoica, I.; Tudorachi, N.; Rusu, A.G.; Nita, L.E.; Chiriac, V.M.; Timpu, D. Comparative Study on the Properties of a Bio-Based Copolymacrolactone System. Polym. Test. 2022, 109, 107555. [Google Scholar] [CrossRef]
- Chiriac, A.P.; Stoleru, E.; Rosca, I.; Serban, A.; Nita, L.E.; Rusu, A.G.; Ghilan, A.; Macsim, A.-M.; Mititelu-Tartau, L. Development of a New Polymer Network System Carrier of Essential Oils. Biomed. Pharmacother. 2022, 149, 112919. [Google Scholar] [CrossRef]
- Rusu, A.G.; Chiriac, A.P.; Nita, L.E.; Ghilan, A.; Rusu, D.; Simionescu, N.; Tartau, L.M. Nanostructured Hyaluronic Acid-Based Hydrogels Encapsulating Synthetic/ Natural Hybrid Nanogels as Promising Wound Dressings. Biochem. Eng. J. 2022, 179, 108341. [Google Scholar] [CrossRef]
- Alvarez Echazú, M.I.; Olivetti, C.E.; Anesini, C.; Perez, C.J.; Alvarez, G.S.; Desimone, M.F. Development and Evaluation of Thymol-Chitosan Hydrogels with Antimicrobial-Antioxidant Activity for Oral Local Delivery. Mater. Sci. Eng. C 2017, 81, 588–596. [Google Scholar] [CrossRef] [PubMed]
- Ehterami, A.; Salehi, M.; Farzamfar, S.; Samadian, H.; Vaez, A.; Ghorbani, S.; Ai, J.; Sahrapeyma, H. Chitosan/Alginate Hydrogels Containing Alpha-Tocopherol for Wound Healing in Rat Model. J. Drug Deliv. Sci. Technol. 2019, 51, 204–213. [Google Scholar] [CrossRef]
- Lavanya, K.; Balagangadharan, K.; Chandran, S.V.; Selvamurugan, N. Chitosan-Coated and Thymol-Loaded Polymeric Semi-Interpenetrating Hydrogels: An Effective Platform for Bioactive Molecule Delivery and Bone Regeneration in Vivo. Biomater. Adv. 2023, 146, 213305. [Google Scholar] [CrossRef]
- Garg, A.; Ahmad, J.; Hassan, M.Z. Inclusion Complex of Thymol and Hydroxypropyl-β-Cyclodextrin (HP-β-CD) in Polymeric Hydrogel for Topical Application: Physicochemical Characterization, Molecular Docking, and Stability Evaluation. J. Drug Deliv. Sci. Technol. 2021, 64, 102609. [Google Scholar] [CrossRef]
- Alsakhawy, S.A.; Baghdadi, H.H.; El-Shenawy, M.A.; Sabra, S.A.; El-Hosseiny, L.S. Encapsulation of Thymus Vulgaris Essential Oil in Caseinate/Gelatin Nanocomposite Hydrogel: In Vitro Antibacterial Activity and in Vivo Wound Healing Potential. Int. J. Pharm. 2022, 628, 122280. [Google Scholar] [CrossRef]
- Malka, E.; Caspi, A.; Cohen, R.; Margel, S. Fabrication and Characterization of Hydrogen Peroxide and Thymol-Loaded PVA/PVP Hydrogel Coatings as a Novel Anti-Mold Surface for Hay Protection. Polymers 2022, 14, 5518. [Google Scholar] [CrossRef]
- Afrin Shefa, A.; Park, M.; Gwon, J.-G.; Lee, B.-T. Alpha Tocopherol-Nanocellulose Loaded Alginate Membranes and Pluronic Hydrogels for Diabetic Wound Healing. Mater. Des. 2022, 224, 111404. [Google Scholar] [CrossRef]
- Jones, E.M.; Cochrane, C.A.; Percival, S.L. The Effect of PH on the Extracellular Matrix and Biofilms. Adv. Wound Care 2015, 4, 431–439. [Google Scholar] [CrossRef]
- Darabian, B.; Bagheri, H.; Mohammadi, S. Improvement in Mechanical Properties and Biodegradability of PLA Using Poly(Ethylene Glycol) and Triacetin for Antibacterial Wound Dressing Applications. Prog. Biomater. 2020, 9, 45–64. [Google Scholar] [CrossRef]
- You, S.; Huang, Y.; Mao, R.; Xiang, Y.; Cai, E.; Chen, Y.; Shen, J.; Dong, W.; Qi, X. Together Is Better: Poly(Tannic Acid) Nanorods Functionalized Polysaccharide Hydrogels for Diabetic Wound Healing. Ind. Crops Prod. 2022, 186, 115273. [Google Scholar] [CrossRef]
- Li, Y.; Fu, R.; Duan, Z.; Zhu, C.; Fan, D. Adaptive Hydrogels Based on Nanozyme with Dual-Enhanced Triple Enzyme-Like Activities for Wound Disinfection and Mimicking Antioxidant Defense System. Adv. Healthc. Mater. 2022, 11, 2101849. [Google Scholar] [CrossRef]
- Yang, Y.; Xu, H.; Li, M.; Li, Z.; Zhang, H.; Guo, B.; Zhang, J. Antibacterial Conductive UV-Blocking Adhesion Hydrogel Dressing with Mild On-Demand Removability Accelerated Drug-Resistant Bacteria-Infected Wound Healing. ACS Appl. Mater. Interfaces 2022, 14, 41726–41741. [Google Scholar] [CrossRef] [PubMed]
- Bauer, A.W.; Perry, D.M.; Kirby, W.M. Single-Disk Antibiotic-Sensitivity Testing of Staphylococci; an Analysis of Technique and Results. AMA Arch. Intern. Med. 1959, 104, 208–216. [Google Scholar] [CrossRef] [PubMed]
- Clinical and Laboratory Standards Institute (CLSI). Performance Standards for Anti-Microbial Susceptibility Testing, 32nd ed.; CLSI Supplement M100 (ISBN 978-1-68440-134-5 [Print]; ISBN 978-1-68440-135-2 [Electronic]); Clinical and LaboraTory Standards Institute: Malvern, PA, USA, 2022. [Google Scholar]
- Brand-Williams, W.; Cuvelier, M.E.; Berset, C. Use of a Free Radical Method to Evaluate Antioxidant Activity. LWT-Food Sci. Technol. 1995, 28, 25–30. [Google Scholar] [CrossRef]
- XLSTAT. Statistical Software for Excel. Available online: https://www.xlstat.com/en/ (accessed on 28 November 2022).

| Scaffold Material | Bioactive Compounds | Cumulative Bioactive Compound Release in Different Release Media | Reference | |
|---|---|---|---|---|
| Thy | α-Tcp | |||
| Chitosan hydrogels | ✓ | - | ~ 70% of Thy release in artificial saliva and ~ 45% of Thy release in phosphate-buffered saline (PBS) after 4 h; 100% of Thy release in almost 48 h | [24] |
| Sodium alginate/chitosan hydrogels | - | ✓ | 37.9 ± 5.18% of α-Tcp release in simulated body fluid after 24 h; a sustained release of 77.2 ± 11.51% over 14 days | [25] |
| Sodium alginate/poly(2-ethyl-2-oxazoline) chitosan-coated semi-interpenetrating hydrogels | ✓ | - | 78.1 ± 1.7% of Thy release in PBS after 25 days | [26] |
| Hydroxypropyl-β-cyclodextrin hydrogels | ✓ | - | 73.4–98.9% of Thy release in PBS, 7.4 after 6 h | [27] |
| Sodium caseinate/gelatin nanocomposite hydrogel | ✓ | - | 71% of thyme essential oil in PBS, 7.4 supplemented with 20% ethanolafter 72 h | [28] |
| PVA/pyrrolidone hydrogel | ✓ | - | 70% of Thy release in ethanol solution after 5 days | [29] |
| Pluronic® F-127/nanocellulose hydrogel | - | ✓ | 100% of α-Tcp release in 8 days | [30] |
| Sample | Inhibition Zone (mm) * | ||
|---|---|---|---|
| S. aureus | E. coli | C. albicans | |
| PVA_PEBSA25/75_Thy_α-Tcp | 22.30 ± 0.14 | 21.90 ± 0.99 | 38.55 ± 1.48 |
| PVA_PEBSA50/50_Thy_α-Tcp | 21.10 ± 0.00 | 19.15 ± 1.06 | 32.25 ± 3.18 |
| PVA_PEBSA75/25_Thy_α-Tcp | 25.90 ± 0.70 | 25.45 ± 3.46 | 34.65 ± 0.91 |
| PVA_PEBSA50/50_2xThy_α-Tcp | 27.05 ± 0.63 | 28.40 ± 0.14 | 37.80 ± 0.28 |
| PVA_PEBSA50/50_Thy_2xα-Tcp | 21.80 ± 3.25 | 19.20 ± 0.00 | 28.25 ± 0.77 |
| Sample | PVA/PEBSA Ratio | Composition for a Volume of 5 mL Sample | |||
|---|---|---|---|---|---|
| PVA (g) | PEBSA (g) | Thymol (g) | α-Tocopherol (g) | ||
| PVA_PEBSA25/75_Thy_α-Tcp | 2/1 | 0.132 | 0.066 | 0.066 | 0.066 |
| PVA_PEBSA50/50_Thy_α-Tcp | 0.066 | 0.066 | |||
| PVA_PEBSA75/25_Thy_α-Tcp | 0.066 | 0.066 | |||
| PVA_PEBSA50/50_2xThy_α-Tcp | 0.132 | 0.066 | |||
| PVA_PEBSA50/50_Thy_2xα-Tcp | 0.066 | 0.132 | |||
Disclaimer/Publisher’s Note: The statements, opinions and data contained in all publications are solely those of the individual author(s) and contributor(s) and not of MDPI and/or the editor(s). MDPI and/or the editor(s) disclaim responsibility for any injury to people or property resulting from any ideas, methods, instructions or products referred to in the content. |
© 2023 by the authors. Licensee MDPI, Basel, Switzerland. This article is an open access article distributed under the terms and conditions of the Creative Commons Attribution (CC BY) license (https://creativecommons.org/licenses/by/4.0/).
Share and Cite
Crețu, B.-E.-B.; Rusu, A.G.; Ghilan, A.; Rosca, I.; Nita, L.E.; Chiriac, A.P. Cryogel System Based on Poly(vinyl alcohol)/Poly(ethylene brassylate-co-squaric acid) Platform with Dual Bioactive Activity. Gels 2023, 9, 174. https://doi.org/10.3390/gels9030174
Crețu B-E-B, Rusu AG, Ghilan A, Rosca I, Nita LE, Chiriac AP. Cryogel System Based on Poly(vinyl alcohol)/Poly(ethylene brassylate-co-squaric acid) Platform with Dual Bioactive Activity. Gels. 2023; 9(3):174. https://doi.org/10.3390/gels9030174
Chicago/Turabian StyleCrețu, Bianca-Elena-Beatrice, Alina Gabriela Rusu, Alina Ghilan, Irina Rosca, Loredana Elena Nita, and Aurica P. Chiriac. 2023. "Cryogel System Based on Poly(vinyl alcohol)/Poly(ethylene brassylate-co-squaric acid) Platform with Dual Bioactive Activity" Gels 9, no. 3: 174. https://doi.org/10.3390/gels9030174
APA StyleCrețu, B.-E.-B., Rusu, A. G., Ghilan, A., Rosca, I., Nita, L. E., & Chiriac, A. P. (2023). Cryogel System Based on Poly(vinyl alcohol)/Poly(ethylene brassylate-co-squaric acid) Platform with Dual Bioactive Activity. Gels, 9(3), 174. https://doi.org/10.3390/gels9030174

